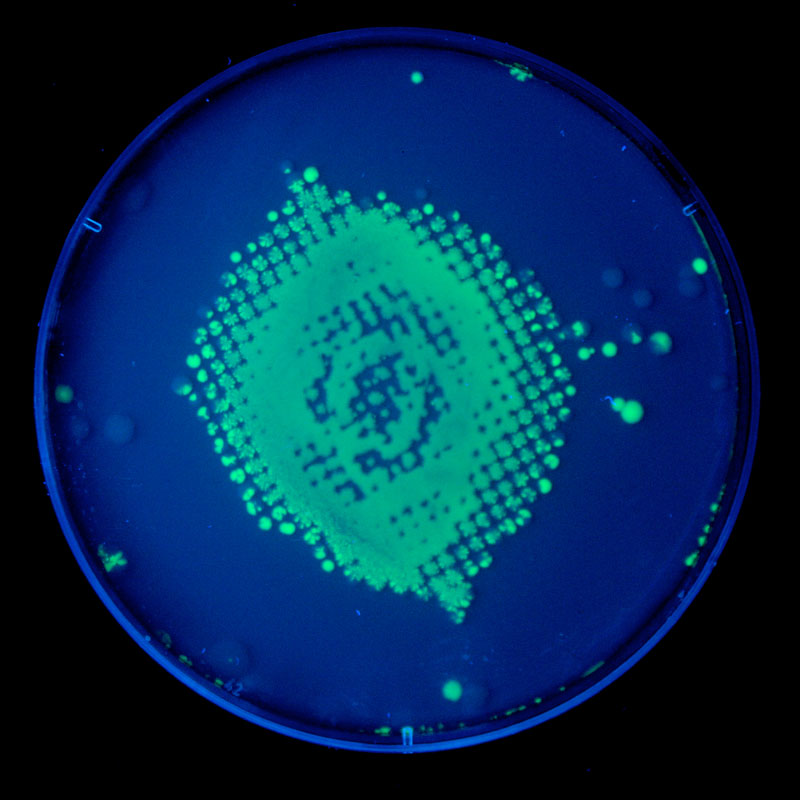

Gallery: Microbes Make Glowing Galaxies & Other Art

Milky Way Microbes

Artist and former microbiologist Zachary Copfer uses bacteria, given genes that make them fluorescent, to create images, such as this one of the Milky Way Galaxy. These pieces were inspired by Carl Sagan's term "star stuff," which refers to the concept that living things, including humans, are made of atoms created in stars.
Egg Nebula

For his Star Stuff series, Copfer used images taken by the Hubble Telescope. Above is the bacterial version of the Egg Nebula. He uses radiation to create an image by sterilizing patches of bacteria spread inside a Petri dish, creating what will become the dark spots within the image. He calls this process bacteriography because it is a photographic process.
Cat's Eye Nebula
This image shows the Cat's Eye Nebula. Copfer puts genes that produce a fluorescent protein into the E. coli bacteria. This allows them to emit visible light when exposed to a black, or ultraviolet, light.
Darwin in Red Microbes

Using a similar process, Copfer created portraits of scientists and artists who have inspired him, such as Charles Darwin, shown above. To create these he grew the red bacterium Serratia marcescens.
The Artist

Zachary Copfer poses with his version of a famous photo of Albert Einstein. When displaying his portraits, he plays with the relationship between art and science by labeling Einstein and Darwin as his favorite artists, and artists Pablo Picasso and Leonardo da Vinci as his favorite scientists.
Einstein in a Petri Dish

A smaller version of Copfer's Einstein portrait.
Art and Science

Copfer sees the same thinking behind both art and science. He says: "Picasso and Einstein were working with the same idea, looking at three-dimensional space from different perspectives, Einstein from the Theory of Relativity and Picasso with cubism."
Get the world’s most fascinating discoveries delivered straight to your inbox.


 Live Science Plus
Live Science Plus





